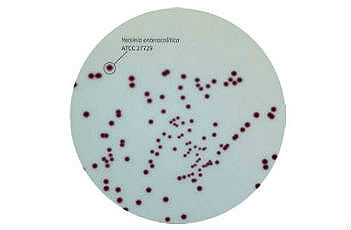

导航
导航
小肠结肠炎耶尔森氏菌是一种可引起急性胃肠炎型食物中毒的病原菌,可致人畜患病。该菌属于耶尔森菌属,主要感染症状表现为发热、腹痛、腹泻、呕吐、关节炎、败血症等。
感染该菌的典型症状常为胃肠炎症状、发热、亦可引起阑尾炎。有的引起反应性关节炎,另一个并发症是败血症,即血液系统感染,死亡率较高。本菌对易染人群为婴幼儿,常引起发热、腹痛和带血的腹泻。
小肠结肠炎耶尔森氏菌主要是通过污染的饮水和食品经消化道传播,感染人体引发疾病,甚至死亡。该菌分布广泛,可存在于蔬菜、乳制品、肉类、豆制品、海产品。也存在于环境中,如湖泊、河流、土壤和植被,或家畜、狗、猫、鼠类等动物的粪便中。在医院中,小肠结肠炎耶尔森氏菌也可通过病人或健康带菌者进一步传播和感染。
Himedia公司生产的耶尔森菌显色培养基(货号:M2025,品名:HiCrome™ Yersinia Agar Base)用于选择性分离食品和临床样本中的小肠结炎耶尔森氏菌。
该显色培养基添加了选择性抑制剂,在显色鉴定上进行了改进。该培养基富含营养因子,同时具有高度选择性。22-32℃培养24-48小时后,显色剂被耶尔森菌裂解,使耶尔森菌菌落为紫色,其他菌被抑制生长或者菌落为无色。
M2020符合《欧洲议会和欧盟理事会体外诊断医疗器械指令》(98/79/EC)的强制实行法规规定。也符合在我国《食品安全国家标准-小肠结肠炎耶尔森氏菌检验》 (GB 4789.8-2016)中,对典型菌落的形态描述要求。
HiCrome是Himedia公司生产的系列显色培养基,目前已有80多种配方,几乎涵盖了大多数常见的菌种检测。HiCrome系列显色培养基相较海内外大多数培养基产品,价格更低且货期稳定。大部分HiCrome显色培养基还有即用型,不需要自己配置,快速便捷,安全稳定,到货即用。
扫二维码用手机看
亚洲精品无码成人A片色欲-性视频播放免费视频-这里是国产精品视频一区二区-久久精品人妻av-国产丰满老熟妇乱XXX
公司地址:河南省濮阳县工业园区中稹绿探办公楼二层
联系电话:13137349799
E-mail:[email protected]
性视频播放免费视频
公司地址:河南省濮阳县工业园区中稹绿探办公楼二层
联系电话:18500199761
E-mail:[email protected]
© 2021 亚洲精品无码成人A片色欲-性视频播放免费视频-这里是国产精品视频一区二区-久久精品人妻av-国产丰满老熟妇乱XXX ALL Rights Reserved 备案号:豫ICP备2023018085号 技术支持:新网